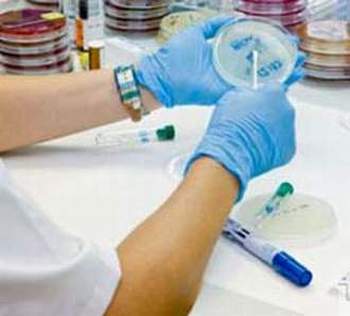

Điểm mặt một số “lực sĩ siêu hạng”
Kháng sinh chống lao: rifamycin, rifampicin, streptomycin, kanamycin, capreomycin, viomycin, cycloserin. Các kháng sinh này phải dùng kết hợp với thuốc kháng lao tổng hợp như isoniazid, ethambutol, pyrazinamid, ethionamid và thực hiện chiến lượng DOTS (điều trị hóa trị liệu ngắn ngày có kiểm soát).
Kháng sinh chống nấm: Nhóm 1 có nifstatin trị nấm Candida ngoài da, nấm đường tiêu hóa. Thuốc có thể gây rối loạn tiêu hóa. Amphoteracin B trị nấm sâu đường toàn thân bằng cách tiêm truyền. Thuốc có thể gây sốt, đau đầu, buồn nôn, nôn, sốc, viêm tĩnh mạch huyết khối. Nhóm 2 có griseofulvin tác dụng kìm nấm microsporium, epidermophyton, triclophyton. Dùng thuốc có thể bị nhức đầu, rối loạn tiêu hóa, phát ban.
Kháng sinh trị khối u (ung thư): Phổ biến là dùng bleomycin dùng trong ung thư biểu mô, bệnh hodfkin, u bạch huyết bào, u ác tính tinh hoàn. Tác dụng phụ: gây suy thận, thiểu năng hô hấp.
- Daunomycin, doxorubicin dùng trong bệnh bạch cầu, lymphô bào cấp, u bạch huyết bào cấp, u nguyên bào thần kinh, u ác tính bàng quang, phổi buồng trứng, tuyến giáp trạng. Tác dụng phụ: ban đỏ da, suy tim, suy tủy, rối loạn tiêu hóa, rụng lông tóc.
- Mytomycin C: điều trị ung thư vú, dạ dày, tụy, bàng quang, phổi, bạch cầu.
Tác dụng phụ: suy tủy, suy giảm xương, giảm bạch cầu, giảm bạch cầu tiểu cầu, tổn thương thận, phổi.
Còn một số kháng sinh chống ung thư khác ít được dùng như dactinomycin, peplomycin, streptozocin.
Ngoài ra có một số thuốc kháng sinh riêng biệt không có cấu trúc giống nhóm nào trên đây: vancomycin, teicoplanin có tác dụng với vi khuẩn gram dương nhưng độc tính cao, novobiocin tác dụng với tụ cầu khuẩn, cầu khuẩn gram âm nhưng thuốc dễ bị vi khuẩn kháng lại, gây rối loạn tiêu hóa; fosfomycin tác dụng với tụ cầu vàng, liên cầu, phế cầu, Escherichia coli, enterobacter… thuốc phải dùng đường tiêm, ít sử dụng.
 Kháng sinh đã đóng góp lớn lao vào việc hạ thấp tỷ lệ tử vong trong các bệnh nhiễm khuẩn. |
“Siêu hạng” cũng chịu bó tay?
Việc nhận biết vi khuẩn kháng kháng sinh không chỉ là y giới mà mọi người đều thấy. Hiệu lực của kháng sinh đã bị giảm nhiều ở hầu hết các nhóm thuốc. Cũng thật dễ hiểu, kháng sinh do vi khuẩn tiết ra, con người chiết xuất được lại dùng để diệt vi khuẩn, nhà “siêu hạng” chẳng lẽ chịu bó tay?
Cơ chế kháng đó là do chúng tiết ra những chất như enzym (betalactamase, cefalosporinase…) để phân hủy kháng sinh, chúng làm thay đổi tính thẩm thấu của thuốc, làm thay đổi bìa tác dụng (protein tiếp nhận đặc hiệu), tạo đường chuyển hóa mới…
Chiến đấu với kẻ thù giấu mặt (không nhìn thấy bằng mắt thường), đông đúc, siêu hạng vì không cần labô hiện đại, đồ sộ, phức tạp là cuộc chiến đấu không cân sức – con người còn đang và luôn luôn là kẻ bị động.
Sử dụng kháng sinh thế nào cho đúng?
Kháng sinh đã đóng góp lớn lao vào việc hạ thấp tỷ lệ tử vong trong các bệnh nhiễm khuẩn. Nhưng hiện nay việc sử dụng kháng sinh tràn lan, bừa bãi đã đưa đến và sẽ còn đưa đến những hậu họa nặng nề.
Việc đưa ra một chiến lược về phát triển, quản lý sử dụng kháng sinh ở cấp độ Nhà nước đã đến lúc cấp thiết. Trước mắt, để ngăn chặn phần nào hậu họa, việc sử dụng kháng sinh là một khâu khá then chốt cần được tính đến.
Làm kháng sinh đồ. |
Dùng kháng sinh phải xác định được là một bệnh nhiễm khuẩn và vi khuẩn gây bệnh. Tốt nhất là cần xét nghiệm và làm kháng sinh đồ. Nếu không có điều kiện làm cần có thầy thuốc thăm khám chỉ định (lâm sàng, kinh ghiệm, điều tra). Bệnh do virut không dùng kháng sinh.
Xem xét kỹ người bệnh: giới, tuổi, tiền sử bệnh (dị ứng, bệnh gan, thận, thần kinh, bệnh khác…) có thai, nuôi con bú… để chỉ định và liều lượng thích hợp.
Chọn kháng sinh phù hợp theo tính năng, tác dụng, hấp thụ, chuyển hóa, khuếch tán, đào thải. Hiện trên lâm sàng, sinh học, vi khuẩn là đã khỏi bệnh mới thôi dùng thuốc.
Luôn theo dõi kết quả sử dụng, nếu không có kết quả phải xem lại chẩn đoán. Chọn lựa thuốc liều lượng dùng, phối hợp với các thuốc khác, điều kiện thâm nhập khuếch tán kháng sinh tới ổ nhiễm khuẩn kể cả cơ địa người bệnh.
 Sơ đồ kháng thuốc của vi khuẩn. |
Không phối hợp nhiều thuốc kháng sinh, chỉ nên dùng loại phổ hẹp, tránh tạo ra nhiều vi khuẩn kháng thuốc, tăng độc tính và tai biến. Nếu phối hợp phải chú ý tương tác giữa các kháng sinh (tương kỵ, kháng chéo, hiệp đồng).
Không dùng kháng sinh dự phòng. Trừ một số trường hợp phẫu thuật có nguy cơ nhiễm khuẩn cao (phẫu thuật tim, ruột già, đường mật, tử cung…). Thuốc thường dùng là penicillin hoặc cephalosporin thế hệ thứ 2. Dùng ngay trước khi lên phòng mổ hoặc lúc bắt đầu rạch dao. Có thể dùng dự phòng trong trường hợp có khả năng hoại thư, dịch tả, tái nhiễm thấp khớp.
Phải luôn luôn chú ý tai biến và tác dụng phụ của kháng sinh: do nhiễm độc (suy gan, thận, thần kinh, tủy, răng, tai…) do vi khuẩn (tạp khuẩn cộng tồn, loạn khuẩn, nội độc tố), tai biến chọn lọc (viêm gan, đứt gân achille, mất bạch cầu, suy tủy, điếc). Đáng chú ý nhất là tai biến do dị ứng, đặc biệt phản ứng phản vệ với người cơ địa dị ứng. Làm test phản ứng và có đầy đủ các phương tiện cấp cứu tại chỗ khi tiêm thuốc kháng sinh.
DS. Ngô Trang

